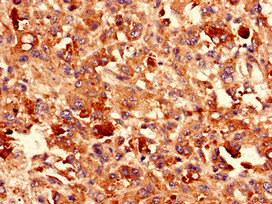
CSB-PA10715A0Rb

CDH3
CDH3,即鈣黏蛋白3(Cadherin-3)又稱P-鈣黏蛋白,是鈣黏蛋白家族的重要成員,通過鈣離子依賴的細胞黏附機制參與組織形態發生和上皮屏障形成。該蛋白在胚胎發育期廣泛分布于胎盤、皮膚等組織,成年后主要表達于乳腺、前列腺等腺體基底細胞層。P-鈣黏蛋白通過與β-catenin等胞內蛋白結合,調控Wnt信號通路活性,影響細胞極性和遷移能力。臨床上,CDH3異常表達與侵襲性乳腺癌(尤其是三陰性亞型)、胃癌轉移密切相關,其過表達可能通過破壞細胞間連接促進腫瘤擴散。在皮膚病領域,CDH3基因突變已被證實是先天性厚甲癥4B型的致病原因。目前針對P-鈣黏蛋白的藥物研發尚處早期階段,部分研究團隊正在探索單克隆抗體和CAR-T細胞療法在乳腺癌治療中的應用潛力。
熱銷產品
CDH3 Antibody (CSB-PA10715A0Rb)
驗證數據
Immunohistochemistry analysis of human melanoma using CSB-PA10715A0Rb at dilution of 1:100

Immunofluorescent analysis of HepG2 cells using CSB-PA10715A0Rb at dilution of 1:100 and Alexa Fluor 488-congugated AffiniPure Goat Anti-Rabbit IgG(H+L)
CDH3 Antibodies
CDH3 for Homo sapiens (Human)
| 產品貨號 | 產品名稱 | 種屬反應性 | 應用類型 |
|---|---|---|---|
| CSB-PA005052GA01HU | CDH3 Antibody | Human,Mouse,Rat | ELISA,WB,IHC |
| CSB-PA10715A0Rb | CDH3 Antibody | Human | ELISA, IHC, IF |
| CSB-PA006358 | CDH3 Antibody | Human | WB, IHC, ELISA |
| CSB-PA037292 | CDH3 Antibody | Human | ELISA,WB |
| CSB-PA196946 | CDH3 Antibody | Human,Mouse | ELISA,WB,IHC |
CDH3 Proteins
CDH3 Proteins for Homo sapiens (Human)
| 產品貨號 | 產品名稱 | 來源 |
|---|---|---|
| CSB-YP005052HU1 CSB-EP005052HU1 CSB-BP005052HU1 CSB-MP005052HU1 CSB-EP005052HU1-B |
Recombinant Human Cadherin-3 (CDH3), partial | Yeast E.coli Baculovirus Mammalian cell In Vivo Biotinylation in E.coli |
| CSB-CF005052HU | Recombinant Human Cadherin-3 (CDH3) | in vitro E.coli expression system |
CDH3 ELISA Kit
CDH3 ELISA Kit for Homo sapiens (Human)
| 產品貨號 | 產品名稱 | 樣本類型 | 靈敏度 |
|---|---|---|---|
| CSB-E08955h | Human Placenta Cadherin,P-cad ELISA Kit | Request Information |











